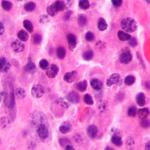
CanerOrgUa's tweet image. Миеломная #болезнь – множественная #миелома - cancer.org.ua/oncohematology…

#новости #онкология #cancer

Новые возможности диагностики при раке предстательной железы #онкология #cancer #рак cancer.org.ua/novyie-vozmozh…

#Рак и #беременность - опасности для матери и ребенка при онкологических заболеваниях cancer.org.ua/cancer-and-pre…

Мобильные телефоны и риск заболеть раком - cancer.org.ua/mobile-phones-… #новости #онкология #cancer

Советы для профилактики #рак #кожи. #Никотинамид может снизить риск развития рака кожи - cancer.org.ua/tips-for-preve…

Медуллобластома - злокачественная врождённая опухоль мозга cancer.org.ua/neurooncology/… #новости #онкология #cancer

Способствует ли алкоголь развитию рака? cancer.org.ua/does-alcohol-c… #новости #онкология #cancer

5 вещей, которые вы должны знать о травах и добавках cancer.org.ua/5-things-you-s… #новости #онкология #cancer


Злокачественная #шваннома (нейрофибросаркома, нейрогенная саркома) - cancer.org.ua/neurooncology/… #онкология #cancer

#Рак у детей – #детская онкология - cancer.org.ua/pediatric-onco… #новости #онкология #cancer

#Глиобластома - самая злокачественная опухоль головного мозга - cancer.org.ua/neurooncology/… #новости #онкология #cancer

Влияние экологического на развитие онкозаболеваний - cancer.org.ua/vliyanie-ekolo… #новости #онкология #cancer

Онкологические клиники, центры и диспансеры в Украине - cancer.org.ua/hospitals/ #новости #онкология #cancer
Миеломная #болезнь – множественная #миелома - cancer.org.ua/oncohematology… #новости #онкология #cancer
United States Trends
- 1. Harbaugh 117 B posts
- 2. #WWENXT 16,4 B posts
- 3. Demond Williams 3.586 posts
- 4. #RHOSLC 7.615 posts
- 5. #TheRookie 15,7 B posts
- 6. Kingston Flemings N/A
- 7. #Isles 3.332 posts
- 8. Darryn Peterson N/A
- 9. Devils 12,1 B posts
- 10. Trey Murphy 1.767 posts
- 11. Markstrom 1.609 posts
- 12. Oba Femi 5.925 posts
- 13. Pelicans 5.141 posts
- 14. #NewYearsEvil 7.240 posts
- 15. Mitch Johnson N/A
- 16. Duke 30,8 B posts
- 17. Cam Spencer 1.208 posts
- 18. Islanders 4.142 posts
- 19. Usha 14,7 B posts
- 20. Thea 6.947 posts
Something went wrong.
Something went wrong.
































